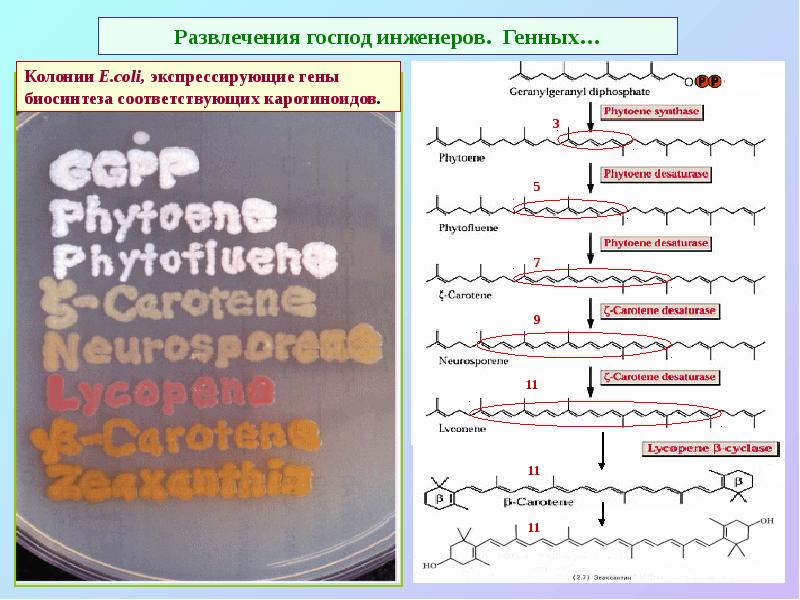
Развлечения господ инженеров. Генных… Развлечения господ инженеров. Генных…

Фотосинтез. Что делать, когда все, что можно, уже окислилось презентация
Содержание
- 3. Хлорофилл: двуликий Янус Red-Ox реакций Хлорофиллов >10: Хл. а, b,
- 4. Различия между хлорофиллами
- 5. Основные структурные особенности молекулы хлорофилла Конъюгированная система двойных связей: основная 18-членная
- 6. δ-амнолевулиновая кислота – проедшественник гема и хлорофиллов.
- 7. Спектры поглощения хлорофиллов
- 8. Энергетические уровни хлорофилла
- 9. Белковое окружение изменяет спектр поглощения хлорофилла
- 10. Первичные процессы фотосинтеза – временные интервалы различаются на 6 -7 порядков
- 11. Простейшая схема фотосинтеза - пурпурные бактерий.
- 12. Вторая простейшая схема фотосинтеза - серные зеленые бактерий.
- 13. Очередная проблема: где взять источник (донор) электронов (окисляемое соединение)? Основные требования
- 14. Как решить проблемы водички в качестве донора электрона? Энергия квантов видимого
- 15. Гениальное решение: соединить две фотосистемы!
- 16. Z-схема: оптимальное сочетание фотосистем позволяет «втиснуть» между ними еще и b6f-комплекс
- 17. Кофакторы ЭТЦ фотосинтеза: знакомые все лица... 2Fe-2S и 4Fe-4S-белки, хиноны (пластохиноны
- 18. Z-схема фотосинтеза.
- 19. Red-Ox потенциалы компонентов ЭТЦ хлоропластов ФСII P680* -
- 20. Организация фотосинтетического аппарата
- 21. Организация фотосинтетического аппарата весьма похожа на ЭТЦ дыхания
- 22. Организация фотосинтетического аппарата, «реальная картинка».
- 23. В6f-комплекс: два такта работы Q-цикла. Как в митохондриях…
- 24. Схема строения белков b6f-комплекса
- 25. В6f-комплекс и структура цитохрома f и FeS-белка Риске
- 26. В6f-комплекс и структура цитохрома f и FeS-белка Риске
- 27. Подвижные переносчики е- фотосинтетической ЭТЦ Пластохиноны (PQ) Eo’ ~ 0v min
- 28. Два типа реакционных центров: феофитин-хиноновый и железо-серный
- 29. Расположение кофакторов в различных реакционных центрах
- 30. Структура RC фотосистемы I 13 белков: А – 83 kDa, 751
- 31. Структура фотосистемы I в «реальном виде»
- 32. Структура реакционного центра пурпурных бактерий (прообраз ФСII)
- 33. Схема RC фотосистемы II 25 белков: D1 - 32 kDa,
- 34. Структура фотосистемы II в «реальном виде».
- 35. Структура белка D1 RC фотосистемы II
- 36. Кинетика работы водоокисляющей системы
- 37. Марганцевый кластер системы фотоокисления воды
- 38. Не все так просто и не все так ясно в системе
- 39. Организация фотосинтетического аппарата, «реальная картинка».
- 40. Антенны. Фикобилисомы: светособирающий комплекс цианобактерий и красных водорослей
- 41. Фикобилипротеиды. По набору пигментов в антенных комплексах, можно заключить что симбиоз
- 42. Светособирающие комплексы различных организмов
- 43. Каротиноиды: каротины и ксантофиллы – тетратерпены (С40) Различия по концевым группам,
- 44. Каротиноиды. Максимумы поглощения, расположение в мембране.
- 45. Развлечения господ инженеров. Генных…
- 46. Хлорофилл-белковые комплексы ФСI и ФСII
- 47. Схема структуры фотосистемы II с антенными комплексами.
- 48. Расположение хромофоров в фотосистеме II Вид со стороны стромы RC:
- 49. Структурная модель ФС II на основе данных кристаллографии
- 50. Светособирающий комплекс LHC II (Lhcb 1&2) : мономер и тример
- 51. Структура фотосистемы II цианобактерий, вид «сбоку» и «сверху»
- 52. Структура «суперкомплекса» фотосистем II c ССК, вид со стороны люмена и
- 53. Фотосистема I со своими светособирающими комплексами (Lhca1 - Lhca4
- 54. Фотосистема I скорее всего существует в виде тримера
- 55. Светособирающие комплексы фотосистем I и II
- 56. LHC II - подвижный светособирающий комплекс
- 57. Гетерогенная организация тилакиодный структур
- 58. Гетерогенная организация тилакиодных структур
- 59. Гетерогенная организация тилакиодный структур
- 60. Гетерогенность расположения компонентов ФСА в тилакоидах
- 62. Механизмы регулирования и защиты ФСII от фотодеструкции нециклический поток, регулирование мобильными
- 63. LHC II - подвижный светособирающий комплекс
- 64. Варианты работы ЭТЦ фотосинтеза
- 65. Циклический транспорт электронов вокруг фотосистемы I и хлоропластное дыхание
- 66. Циклическиe потоки электронов вокруг фотосистемы II
- 67. Функции каротиноидов 1. Антенны (400 – 500 нм) 2. Структурная (организация
- 68. Каротиноиды в хлоропластах 1. Разные состояния: мономерная или агрегированная форма, связь
- 69. Виолоксантиновый цикл –основа NPQ («нефотохимического тушения»)
- 70. Фотозащита. «Переключение» виолоксантиновой системы.
- 71. D1 белок – «камикадзе» растительной клетки Разборка ФС II: уходят белки
- 72. Темновая фаза фотосинтеза – образование «основных фондов» из НАДФН и АТФ
- 73. Восстановительный пентозо-фосфатный цикл (ВПЦ)
- 74. Скачать презентацию

Слайды и текст этой презентации
Скачать презентацию на тему Фотосинтез. Что делать, когда все, что можно, уже окислилось можно ниже:
Похожие презентации





























